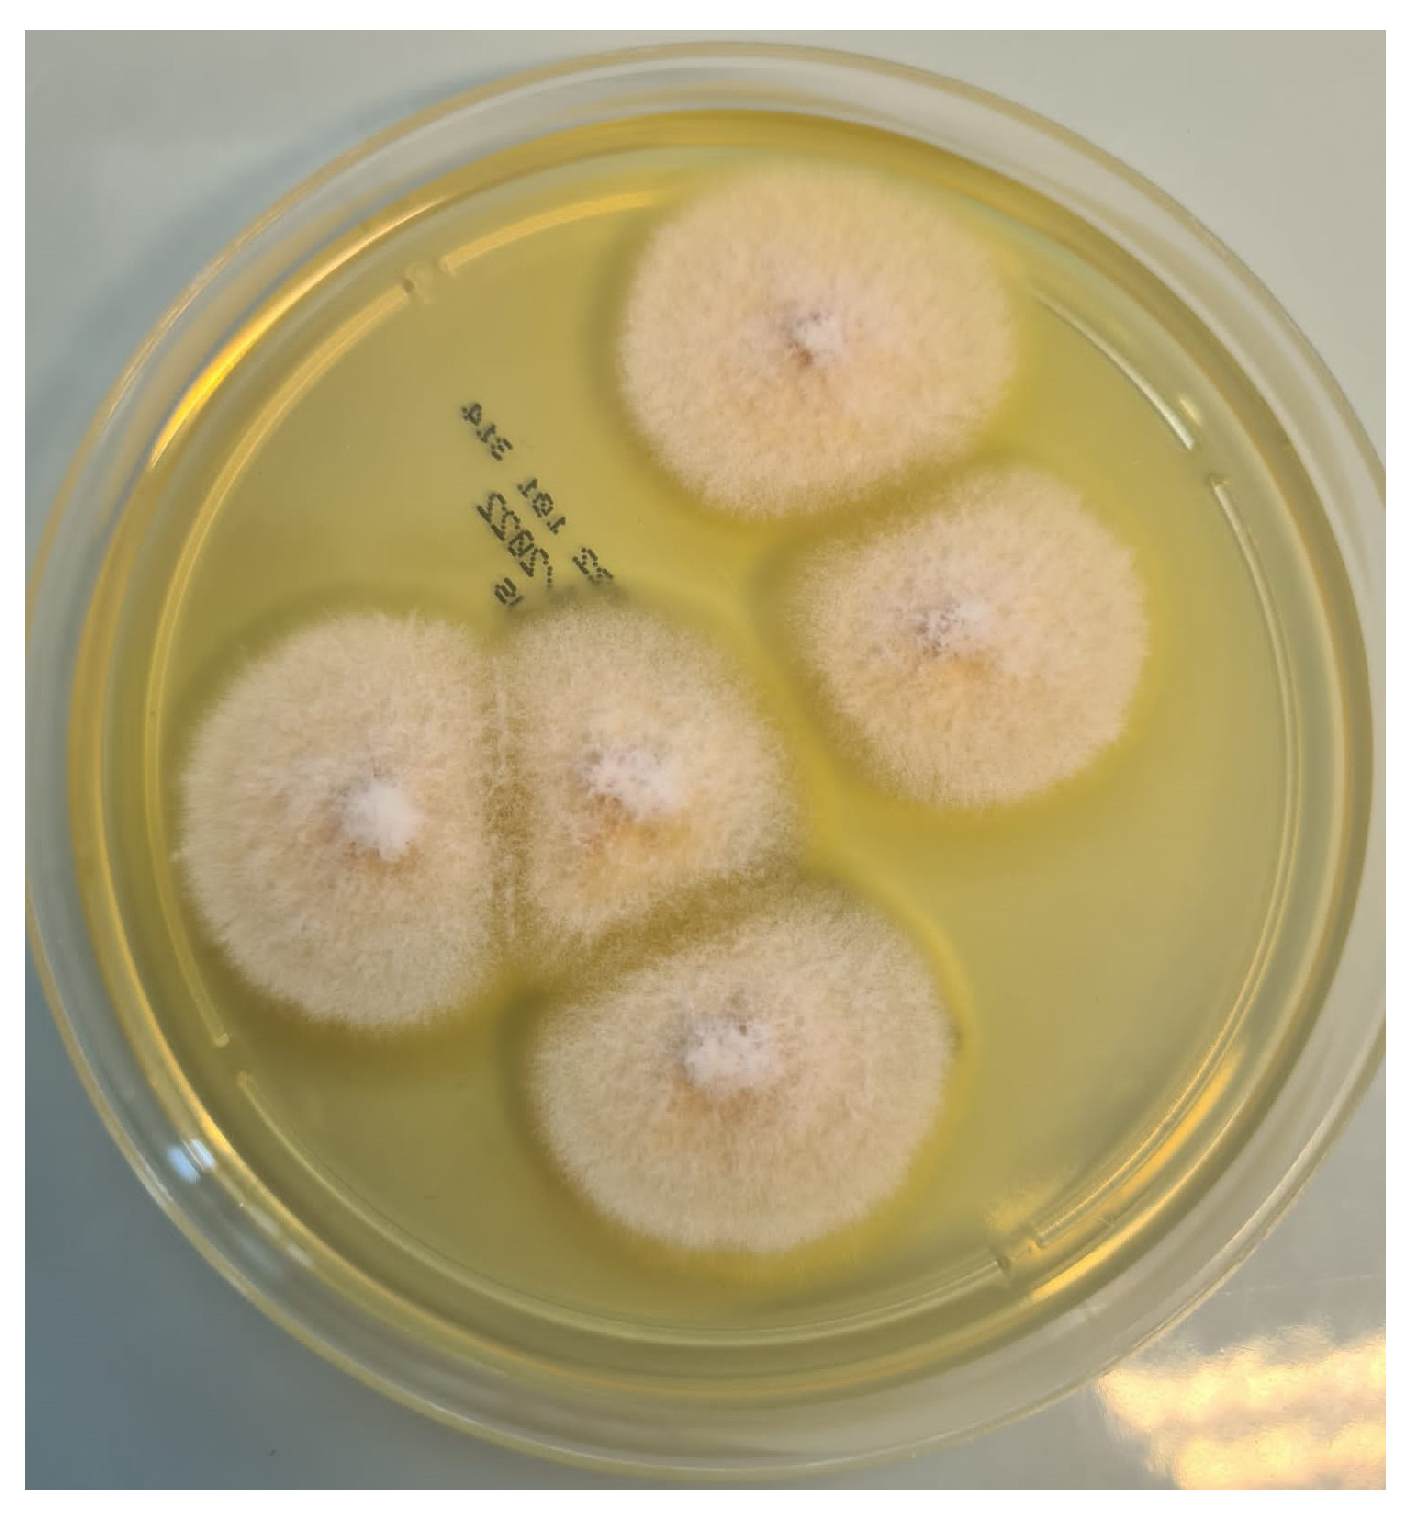
Pathogens 12 00304 g005 Pathogens 12 00304 g005

Mucorales/Fusarium Mixed Infection in Hematologic Patient with COVID-19 Complications: An Unfortunate Combination
Abstract
1. Introduction
2. Case Presentation
3. Discussion
4. Conclusions
Author Contributions
Funding
Institutional Review Board Statement
Informed Consent Statement
Data Availability Statement
Conflicts of Interest
References
- Ceccarelli, M.; Marino, A.; Pulvirenti, S.; Coco, V.; Busà, B.; Nunnari, G.; Cacopardo, B.S. Bacterial and Fungal Co-Infections and Superinfections in a Cohort of COVID-19 Patients: Real-Life Data from an Italian Third Level Hospital. Infect. Dis. Rep. 2022, 14, 372–382. [Google Scholar] [CrossRef]
- Casalini, G.; Giacomelli, A.; Ridolfo, A.; Gervasoni, C.; Antinori, S. Invasive fungal infections complicating COVID-19: A narrative review. J. Fungi 2021, 7, 921. [Google Scholar] [CrossRef]
- Bellanger, A.P.; Rocchi, S.; Berceanu, A.; Scherer, E.; Larosa, F.; Millon, L. Positive quantitative PCR detecting Fusarium solani in a case of mixed invasive fungal disease due to Mucorales and Fusarium solani. Bone Marrow Transplant. 2020, 55, 873–876. [Google Scholar] [CrossRef] [PubMed]
- Nucci, M.; Anaissie, E. Fusarium infections in immunocompromised patients. Clin. Microbiol. Rev. 2007, 20, 695–704. [Google Scholar] [CrossRef]
- Durand-Joly, I.; Alfandari, S.; Benchikh, Z.; Rodrigue, M.; Espinel-Ingroff, A.; Catteau, B.; Cordevant, C.; Camus, D.; Dei-Cas, E.; Bauters, F.; et al. Successful outcome of disseminated Fusarium infection with skin localization treated with voriconazole and amphotericin B-lipid complex in a patient with acute leukemia. J. Clin. Microbiol. 2003, 41, 4898–4900. [Google Scholar] [CrossRef]
- Anaissie, E.; Nucci, M. Cutaneous infection by Fusarium species in healthy and immunocompromised hosts: Implications for diagnosis and management. Clin. Infect. Dis. 2002, 35, 909–920. [Google Scholar] [CrossRef]
- Zhao, B.; He, D.; Wang, L. Advances in Fusarium drug resistance research. J. Glob. Antimicrob. Resist. 2021, 24, 215–219. [Google Scholar] [CrossRef]
- Al-Hatmi, A.M.S.; Meis, J.F.; de Hoog, G.S. Fusarium: Molecular Diversity and Intrinsic Drug Resistance. PLoS Pathog. 2016, 12. [Google Scholar] [CrossRef]
- Walker, L.A.; Gow, N.A.R.; Munro, C.A. Fungal echinocandin resistance. Fungal Genet. Biol. 2010, 47, 117–126. [Google Scholar] [CrossRef] [PubMed]
- Letscher-Bru, V.; Campos, F.; Waller, J.; Randriamahazaka, R.; Candolfi, E.; Herbrecht, R. Successful outcome of treatment of a disseminated infection due to Fusarium dimerum in a leukemia patient. J. Clin. Microbiol. 2002, 40, 1100–1102. [Google Scholar] [CrossRef]
- Skiada, A.; Drogari-Apiranthitou, M.; Pavleas, I.; Daikou, E.; Petrikkos, G. Global Cutaneous Mucormycosis: A Systematic Review. J. Fungi 2022, 8, 194. [Google Scholar] [CrossRef] [PubMed]
- Marino, A.; Zafarana, G.; Ceccarelli, M.; Cosentino, F.; Moscatt, V.; Bruno, G.; Bruno, R.; Benanti, F.; Cacopardo, B.; Celesia, B.M. Immunological and Clinical Impact of DAA-Mediated HCV Eradication in a Cohort of HIV/HCV Coinfected Patients: Monocentric Italian Experience. Diagnostics 2021, 11, 2336. [Google Scholar] [CrossRef]
- Micali, C.; Russotto, Y.; Facciolà, A.; Marino, A.; Celesia, B.M.; Pistarà, E.; Caci, G.; Nunnari, G.; Pellicanò, G.F.; Rullo, E.V. Pulmonary Kaposi Sarcoma without Respiratory Symptoms and Skin Lesions in an HIV-Naïve Patient: A Case Report and Literature Review. Infect. Dis. Rep. 2022, 14, 228–242. [Google Scholar] [CrossRef]
- Guegan, H.; Iriart, X.; Bougnoux, M.E.; Berry, A.; Robert-Gangneux, F.; Gangneux, J.P. Evaluation of MucorGenius® mucorales PCR assay for the diagnosis of pulmonary mucormycosis. J. Infect. 2020, 81, 311–317. [Google Scholar] [CrossRef] [PubMed]
- Diagnosis and Testing of Mucormycosis | Mucormycosis | CDC. Available online: https://www.cdc.gov/fungal/diseases/mucormycosis/diagnosis.html (accessed on 21 November 2022).
- Normand, A.C.; Imbert, S.; Brun, S.; Al-Hatmi, A.M.S.; Chryssanthou, E.; Cassaing, S.; Schuttler, C.; Hasseine, L.; Mahinc, C.; Costa, D.; et al. Clinical Origin and Species Distribution of Fusarium spp. Isolates Identified by Molecular Sequencing and Mass Spectrometry: A European Multicenter Hospital Prospective Study. J. Fungi 2021, 7, 246. [Google Scholar] [CrossRef]
- Nucci, M.; Barreiros, G.; Reis, H.; Paixão, M.; Akiti, T.; Nouér, S.A. Performance of 1,3-beta-D-glucan in the diagnosis and monitoring of invasive fusariosis. Mycoses 2019, 62, 570–575. [Google Scholar] [CrossRef] [PubMed]
- Nucci, M.; Carlesse, F.; Cappellano, P.; Varon, A.G.; Seber, A.; Garnica, M.; Nouér, S.A.; Colombo, A.L. Earlier diagnosis of invasive fusariosis with Aspergillus serum galactomannan testing. PLoS ONE 2014, 9, e87784. [Google Scholar] [CrossRef]
- Trovato, L.; Betta, P.; Romeo, M.G.; Oliveri, S. Detection of fungal DNA in lysis-centrifugation blood culture for the diagnosis of invasive candidiasis in neonatal patients. Clin. Microbiol. Infect. 2012, 18, E63–E65. [Google Scholar] [CrossRef]
- Trovato, L.; Marino, A.; Pizzo, G.; Oliveri, S. Case Report: Molecular Diagnosis of Fungal Keratitis Associated With Contact Lenses Caused by Fusarium solani. Front. Med. 2021, 8, 249. [Google Scholar] [CrossRef]
- Arvanitis, M.; Anagnostou, T.; Fuchs, B.B.; Caliendo, A.M.; Mylonakis, E. Molecular and nonmolecular diagnostic methods for invasive fungal infections. Clin. Microbiol. Rev. 2014, 27, 490–526. [Google Scholar] [CrossRef]
- El-Sokkary, R.; Uysal, S.; Erdem, H.; Kullar, R.; Pekok, A.U.; Amer, F.; Grgić, S.; Carevic, B.; El-Kholy, A.; Liskova, A.; et al. Profiles of multidrug-resistant organisms among patients with bacteremia in intensive care units: An international ID-IRI survey. Eur. J. Clin. Microbiol. Infect. Dis. 2021, 40, 2323–2334. [Google Scholar] [CrossRef] [PubMed]
- Erdem, H.; Hargreaves, S.; Ankarali, H.; Caskurlu, H.; Ceviker, S.A.; Bahar-Kacmaz, A.; Meric-Koc, M.; Altindis, M.; Yildiz-Kirazaldi, Y.; Kizilates, F.; et al. Managing adult patients with infectious diseases in emergency departments: International ID-IRI study. J. Chemother. 2021, 33, 302–318. [Google Scholar] [CrossRef]
- Cosentino, F.; Moscatt, V.; Marino, A.; Pampaloni, A.; Scuderi, D.; Ceccarelli, M.; Benanti, F.; Gussio, M.; Larocca, L.; Boscia, V.; et al. Clinical characteristics and predictors of death among hospitalized patients infected with SARS-CoV-2 in Sicily, Italy: A retrospective observational study. Biomed. Rep. 2022, 16, 34. [Google Scholar] [CrossRef]
- Marino, A.; Munafò, A.; Augello, E.; Bellanca, C.M.; Bonomo, C.; Ceccarelli, M.; Musso, N.; Cantarella, G.; Cacopardo, B.; Bernardini, R. Sarilumab Administration in COVID-19 Patients: Literature Review and Considerations. Infect. Dis. Rep. 2022, 14, 360–371. [Google Scholar] [CrossRef] [PubMed]
- Marino, A.; Pampaloni, A.; Scuderi, D.; Cosentino, F.; Moscatt, V.; Ceccarelli, M.; Gussio, M.; Celesia, B.M.; Bruno, R.; Borraccino, S.; et al. High-flow nasal cannula oxygenation and tocilizumab administration in patients critically ill with COVID-19: A report of three cases and a literature review. World Acad. Sci. J. 2020, 2, 23. [Google Scholar] [CrossRef]
- Campanella, E.; Marino, A.; Ceccarelli, M.; Gussio, M.; Cosentino, F.; Moscatt, V.; Micali, C.; Nunnari, G.; Celesia, B.M.; Cacopardo, B. Pain crisis management in a patient with sickle cell disease during SARS-CoV-2 infection: A case report and literature review. World Acad. Sci. J. 2022, 4, 14. [Google Scholar] [CrossRef]
- Marino, A.; Campanella, E.; Ceccarelli, M.; Larocca, L.; Bonomo, C.; Micali, C.; Munafò, A.; Celesia, B.M.; Nunnari, G.; Cacopardo, B. Sarilumab administration in patients with severe COVID-19: A report of four cases and a literature review. World Acad. Sci. J. 2022, 4, 24. [Google Scholar] [CrossRef]
- Pal, R.; Singh, B.; Bhadada, S.K.; Banerjee, M.; Bhogal, R.S.; Hage, N.; Kumar, A. COVID-19-associated mucormycosis: An updated systematic review of literature. Mycoses 2021, 64, 1452–1459. [Google Scholar] [CrossRef]
- Chiurlo, M.; Mastrangelo, A.; Ripa, M.; Scarpellini, P. Invasive fungal infections in patients with COVID-19: A review on pathogenesis, epidemiology, clinical features, treatment, and outcomes. New Microbiol. 2021, 44, 71–83. [Google Scholar] [PubMed]
- Trovato, L.; Calvo, M.; Migliorisi, G.; Astuto, M.; Oliveri, F.; Oliveri, S. Fatal VAP-related pulmonary aspergillosis by Aspergillus niger in a positive COVID-19 patient. Respir. Med. Case Rep. 2021, 32, 101367. [Google Scholar] [CrossRef]
- Wiederhold, N.P. Antifungal resistance: Current trends and future strategies to combat. Infect. Drug Resist. 2017, 10, 249–259. [Google Scholar] [CrossRef] [PubMed]
- Antinori, S.; Corbellino, M.; Parravicini, C. Challenges in the Diagnosis of Invasive Fungal Infections in Immunocompromised Hosts. Curr. Fungal Infect. Rep. 2018, 12, 12–22. [Google Scholar] [CrossRef] [PubMed]

Disclaimer/Publisher’s Note: The statements, opinions and data contained in all publications are solely those of the individual author(s) and contributor(s) and not of MDPI and/or the editor(s). MDPI and/or the editor(s) disclaim responsibility for any injury to people or property resulting from any ideas, methods, instructions or products referred to in the content. |
© 2023 by the authors. Licensee MDPI, Basel, Switzerland. This article is an open access article distributed under the terms and conditions of the Creative Commons Attribution (CC BY) license (https://creativecommons.org/licenses/by/4.0/).
Share and Cite
Marino, A.; Calvo, M.; Trovato, L.; Scalia, G.; Gussio, M.; Consoli, U.; Ceccarelli, M.; Nunnari, G.; Cacopardo, B. Mucorales/Fusarium Mixed Infection in Hematologic Patient with COVID-19 Complications: An Unfortunate Combination. Pathogens 2023, 12, 304. https://doi.org/10.3390/pathogens12020304
Marino A, Calvo M, Trovato L, Scalia G, Gussio M, Consoli U, Ceccarelli M, Nunnari G, Cacopardo B. Mucorales/Fusarium Mixed Infection in Hematologic Patient with COVID-19 Complications: An Unfortunate Combination. Pathogens. 2023; 12(2):304. https://doi.org/10.3390/pathogens12020304
Chicago/Turabian StyleMarino, Andrea, Maddalena Calvo, Laura Trovato, Guido Scalia, Maria Gussio, Ugo Consoli, Manuela Ceccarelli, Giuseppe Nunnari, and Bruno Cacopardo. 2023. "Mucorales/Fusarium Mixed Infection in Hematologic Patient with COVID-19 Complications: An Unfortunate Combination" Pathogens 12, no. 2: 304. https://doi.org/10.3390/pathogens12020304
APA StyleMarino, A., Calvo, M., Trovato, L., Scalia, G., Gussio, M., Consoli, U., Ceccarelli, M., Nunnari, G., & Cacopardo, B. (2023). Mucorales/Fusarium Mixed Infection in Hematologic Patient with COVID-19 Complications: An Unfortunate Combination. Pathogens, 12(2), 304. https://doi.org/10.3390/pathogens12020304

